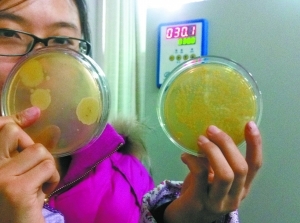

“为了孩子的健康,衣物还是尽量用手洗吧。”近日,一名网友将拆开的洗衣机外筒照片贴在了微博上,引来多人围观。在图片中,洗衣机外筒的内壁上黏附着很多黑色和棕黄色的污物。除了洗衣机,在我们日常生活中经常使用的其他电器,到底有多脏?为此,记者走进北京农学院生物工程与科学学院,在靳永胜博士的指导下,进行了一组细菌对比实验。
实验过程
1
涂抹样品
实验人员先将经过紫外线消毒后的棉签浸润无菌生理盐水,再分别从唐先生家的电动剃须刀网、滚筒洗衣机外筒、冰箱冷藏室、平板电脑、饮水机出水口处取样。取样时所蘸取的面积约为1平方厘米。
2
提取细菌
在用棉签涂抹完需要测试的家电表面后,实验人员将棉签放进5.5毫升的无菌生理盐水中进行80次振荡,同时对样品进行编号。
3
涂抹着床
等到棉签上沾有的细菌溶进生理盐水后,实验人员从样本中各取0.2毫升注入到固体培养基,然后轻轻晃动培养基,让样品中的细菌充分附着到整个培养基表面。
4
恒温繁殖
一切准备就绪,实验人员将固体培养基放进电热恒温培养箱培养,培养箱的温度被设定在30℃,以观察细菌生长。
实验结果
洗衣机外筒最脏
冰箱里细菌种类最多
24小时后,实验人员进行了第一次观察,因细菌繁殖较慢,培养基上没有显示出明显的菌斑。48小时后,实验人员进行了第二次观察,这时的培养基表面开始长出块块菌斑。其中,电动剃须刀网和平板电脑的取样并不明显,但洗衣机外筒、冰箱冷藏室和饮水机出水口处所采集的细菌生长得十分“茂盛”。
记者注意到,取自洗衣机外筒、冰箱冷藏室和饮水机出水口处细菌的培养基上,布满了颗粒状或絮状的黄色或白色菌斑。洗衣机外筒的细菌数量是最多的,记者粗粗估算了一下,菌斑的数量在300个以上。而冰箱冷藏室里的细菌种类最多,至少有3种细菌。
靳永胜博士告诉记者,这些细菌主要是芽孢杆菌、枯草芽孢杆菌、大肠杆菌以及金黄色葡萄球菌。他表示,冰箱冷藏室的样本中培养出大量的金黄色葡萄球菌,此外洗衣机外筒的样本也培养出了金黄色葡萄球菌。
那么,在室温的条件下,黏附在电器表面上的细菌有多少?靳永胜博士用公式进行了简单的计算,以冰箱冷藏室为例,其固体培养基上繁殖出来的菌斑数量为55个。那么,用体积算法,可以推算出其表面含有的细菌总数。
也就是说,1平方厘米的冰箱冷藏室内壁,大约活跃着7500多个小细菌。
靳永胜博士介绍,芽孢杆菌和枯草芽孢杆菌对人体影响不大,真正需要注意的是金黄色葡萄球菌。他表示,金黄色葡萄球菌是一种致病菌,对人体危害较大。根据固体培养基的菌斑颜色推断,冰箱冷藏室的样本中至少有3种细菌。他认为,冰箱冷藏室中之所以能有金黄色葡萄球菌等致病菌,主要是冷藏的肉食发生了腐败而产生的。
需要注意的是,金黄色葡萄球菌是人类化脓感染中最常见的病原菌,可引起局部化脓感染,也可引起肺炎、伪膜性肠炎、心包炎等,甚至败血症、脓毒症等全身感染。
本报记者 王琪鹏 于海波
李环宇 文并摄 J219 J003 J002
建议
洗衣机内筒 半年清一次
海尔家电洗衣机部门的相关负责人告诉记者,滚筒洗衣机外筒发霉是由于没有将水排干净而造成的,这是不可避免的。此外,滚筒洗衣机机箱门内的窗垫内侧容易积聚衣服纤维、毛絮等杂质,时间久了也容易发霉。但是,这些都是可以预防的:每次洗完衣服后再用清水将洗衣机内筒冲洗一遍,然后打开机箱门晾干。另外,还可以定期用洗衣机专用的洗剂清洗,一般建议半年一次。
冰箱冷藏室 常用清水擦
唐先生得知自家冰箱冷藏室内有致病菌后,决定用酒精彻底消毒一次。但是,冰箱内室一定不能用酒精擦拭,也不能用酸性或碱性的清洗剂擦拭,最好的办法就是用清水清洗,平时使用时发现杂污可以随手用湿毛巾擦净,或者定期用清水擦拭。
饮水机内胆 请专业人员清洗
一位饮水机销售员向记者透露,实际上,饮水机的内胆比入水口脏多了。因为内胆里的水垢、细菌则是看不见的,由于经常加热、冷却,内胆里非常适宜水垢、细菌滋生,而且一般消费者很难拆开饮水机外壳,取出内胆清洗。一般建议自费请厂家人员上门拆洗,两三个月清洗一次。

